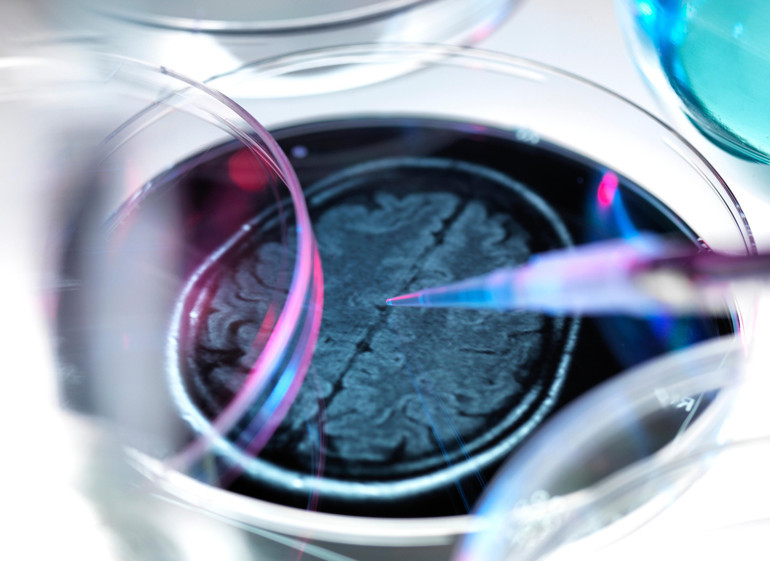
Demansı yaşlılık hastalığı olarak bilirdik… 24 yaşındaki genci nasıl hayattan kopardı

Oluşturulma Tarihi: Ocak 19, 2026 07:47
İngiltere’de yaşayan 24 yaşındaki Andre Yarham, demans (bunama) hastalığından ötürü geçtiğimiz günlerde yaşamını yitirdi. Teşhis konduğunda 22 yaşında olan Yarham’ın ailesi evlatlarının beynini bilimsel araştırmalar yapılması için bağışladı. Hep ileri yaşlarda görülen demans hastalığı nasıl oldu da 20’lerinin başlarındaki bir genç adamı buldu? Demans, gençlerde de görülebilen bir hastalık mı?
Bazı hastalıkları gençlerde görmeye alışkın değiliz. Demans, Parkinson, romatizma gibi hastalıklar genelde orta ve ileri yaş hastalığı olarak ifade edilir. Hal böyleyken 24 yaşında bir genç demanstan ötürü hayatını kaybettiğinde hepimiz bunun nasıl mümkün olabildiğini soruyoruz. Kısa cevabı hemen verelim: Demans pek de yaş ayrımı gözetmeyen bir hastalık ancak gençlerde görülen türleri çok ama çok nadir...
Örneğin Andre Yarham’ın vakasında görülen “frontotemporal demans”, bütün demans hastalıklarının yüzde 10 ila 20’sini oluşturuyor fakat bu orana 45-60 yaş aralığı dahil. Yani 22 gibi bir yaşta görülme sıklığı çok daha düşük.
TEŞHİS İLE VEFAT ARASINDA SADECE İKİ YIL VAR
Andre’nin annesi Samantha Fairbairn, oğlunun davranışlarındaki değişikliği 2022’nin sonlarına doğru fark ettiğini belirterek, o dönem Andre’nin her şeyi unutmaya ve uygunsuz tavırlar sergilemeye başladığını anlattı.
Nöroloji Uzmanı Prof. Dr. Ali Erdemoğlu Andre’nin yakalandığı demans türüne dair değerlendirmesinde, özel bazı demans türlerinin olduğunu ve bu türlerin son derece nadir görüldüğünü söyledi. Bu vakalarda uygunsuz söz, şaka ve davranış görüldüğünü kaydeden Erdemoğlu, “İlgisizlik, sosyal davranış bozuklukları olur. Duygusal körleşmeleri ve bazı takıntılı rutinleri vardır, örneğin aynı yemekleri yerler. Bazı frontotemporal demans vakalarında konuşma bozukluğu ve erken dönemde Parkinson bile çıkabiliyor” değerlendirmesini yaptı.
GENETİK FAKTÖR ETKİLİ Mİ?
Erdemoğlu, “Genelde ailevi bir yaklaşım oluyor” diyerek hastalığın genetik özelliğine dikkat çekti. Frontotemporal demans vakalarının yarısına yakınının ailevi olduğunu kaydeden Erdemoğlu, “O nedenle daha önce ailede genç yaşta demans görüldüyse dikkat etmek gerekir” dedi.
Nöroloji Uzmanı Mehmet Yavuz ise yoğun yasaklı madde kullanımı ya da gribal enfeksiyon geçmişi gibi hastalığı erkene çekebilen durumlara vurgu yaptı.
Demansın genel itibariyle orta ve ileri yaş hastalığı olduğunu ama çok nadir ve münferit olarak böyle hayli erken yaşlarda da ortaya çıkabildiğini söyleyen Yavuz, sözlerini şöyle sürdürdü:
“Tabii bu gencin geçmişini bilmiyoruz ama bazen geçmişinde çok yoğun uyuşturucu madde kullanan kişilerde görülebiliyor. Özellikle son yıllarda bazı uyuşturucuların çok sentetik kombinasyon ihtiva ettiğini biliyoruz. Yasaklı madde kullanımı beyni ciddi manada tahrip ediyor ve demansiyel süreç için ciddi bir zemin oluşturuyor. Normalde 20-30 sene sonra gelişmesi gereken tabloyu çok erkene çekebiliyor.”
Demansa erken yaşlarda yakalanan kişilerin beyin nöronlarını tutan bir viral veya gribal enfeksiyon da geçirmiş olabileceğini ifade eden Yavuz, bu hastalıkların nadiren de olsa ansefalite (beyin iltihabına) dönebildiği bilgisini verdi.
PEKİ BEYİNDE NELER OLUYOR?
Prof. Dr. Erdemoğlu, frontotemporal demansın beyindeki belirli bölgelerde, frontal bölge ile temporal bölgenin bozulmasıyla ortaya çıkan bir demans türü olduğuna vurgu yaparak, bozulmanın genel hücrelerde değil, bölgesel hücrelerde oluştuğunu dile getirdi.
Frontotemporal demans vakalarının çoğunda genetik bileşen görülüyor. Belirli genlerdeki değişiklikler, beyin hücrelerinin proteinleri işleme şeklini bozabiliyor. Bu durumda da söz konusu proteinler parçalanıp geri dönüştürülmek yerine nöronların arasına kümelenebiliyor. Bu da nöronların işlev görme ve hayatta kalma yeteneklerini bozuyor. Özetlemek gerekirse demans tüm bu süreçlerin sonucunda ortaya çıkan bir hastalık. Mehmet Yavuz da tam olarak buna dikkat çekti:
“Demans bir sebep değil, sonuç olduğu için uygulanan tedavi yöntemlerinin çok bir faydası olmuyor.”
Mehmet Yavuz demansın dejeneratif bir hastalık olduğunun altını çizerek, “Erken yaşlarda görülen vakalar tedaviye daha dirençli oluyor” dedi. Nitekim Andre’nin annesi de hastalığın kendilerini çok çaresiz bıraktığını belirterek yaşadıklarını, “Kanser hastaları radyoterapi, kemoterapi görebiliyor. Hastalıkları hafifleyebiliyor ve verimli neticeler elde edilebiliyor. Ama demansta yapacak hiçbir şey yok” sözleriyle anlattı.
BELİRTİLERİ ANLAMAK ÇOK ZOR
Etrafımızda bir genç demasa yakalansa, belirtileri gördüğümüzde ilk aklımıza gelen hastalık demans olmuyor. Öncelikli ihtimaller arasına türlü davranış bozukluklarını ya da farklı bilişsel hastalıkları koyuyoruz. Ali Erdemoğlu'na bunu sorduğumuzda, “Öyle olması gerekiyor zaten, akla ilk başka hastalıkların gelmesi gerekiyor” cevabını verdi.
ANNESİ BİLİMSEL ARAŞTIRMALAR İÇİN ANDRE’NİN BEYNİNİ BAĞIŞLADI
Andre’nin annesi, kaybın ardından oğlunun beynini bilimsel araştırmalar yapılması için bağışladı. Samantha Fairbairn kararını, “İleride ailelerin kıymet verdiği bir yakınıyla birkaç yıl daha fazladan geçirmesine değer” diye açıkladı.
Erdemoğlu da Fairbairn’in oğlunun beynini bağışlama kararının bu konuda yapılacak araştırmalara faydalı olacağını belirtti. Mehmet Yavuz ise araştırmacıların beynin üzerinde incelemeler yaparak hastanın neden bu kadar genç vefat ettiğini araştırabileceğinin altını çizerek, “Sonraki vakalar için yol gösterici olabilir” açıklamasını yaptı.
sidal.utkucu@hurriyet.com.tr

 1 ay önce
30
1 ay önce
30










 English (US) ·
English (US) ·